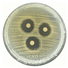
Micro 04 00043 i003
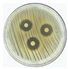
Micro 04 00043 i005
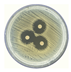
Micro 04 00043 i008
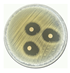
Micro 04 00043 i009
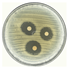
Micro 04 00043 i011
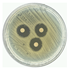
Micro 04 00043 i012

Green Synthesis and Characterization of Silver Nanoparticles from Minthostachys acris Schmidt Lebuhn (Muña) and Its Evaluation as a Bactericidal Agent Against Escherichia coli and Staphylococus aureus
Abstract
:1. Introduction
2. Materials and Methods
2.1. Plant Collection and Characterization
2.2. Plant Extract Preparation
2.3. Green Synthesis of Silver Nanoparticles
2.4. Characterization of Green Synthesized Silver Nanoparticles
2.5. Antimicrobial Activity of Silver Nanoparticles
3. Results and Discussion
3.1. Spectroscopy Characterization
3.2. Physical Characterizations: DLS and SEM Analyses
3.3. Antimicrobial Activity of Silver Nanoparticles
4. Conclusions
Author Contributions
Funding
Data Availability Statement
Acknowledgments
Conflicts of Interest
References
- Lenz, G.F.; Bini, R.A.; Bueno, T.P.; de Oliveira, R.J.; Felix, J.F.; Schneider, R. Self-supported copper (Cu) and Cu-based nanoparticle growth by bottom-up process onto borophosphate glasses. J. Mater. Sci. 2017, 52, 6635–6646. [Google Scholar] [CrossRef]
- Lenz, G.F.; Schneider, R.; Rossi de Aguiar, K.M.F.; Bini, R.A.; Chaker, J.A.; Hammer, P.; Botteselle, G.V.; Felix, J.F.; Schneider, R. Self-supported nickel nanoparticles on germanophosphate glasses: Synthesis and applications in catalysis. RSC Adv. 2019, 9, 17157–17164. [Google Scholar] [CrossRef] [PubMed]
- Locatelli, P.P.; Gurtat, M.; Lenz, G.F.; Marroquin, J.F.R.; Felix, J.F.; Schneider, R.; Borba, C.E. Simple borophosphate glasses for on-demand growth of self-supported copper nanoparticles in the reduction of 4-nitrophenol. J. Hazard. Mater. 2021, 416, 125801. [Google Scholar] [CrossRef] [PubMed]
- Vilchis-Nestor, A.R.; Sánchez-Mendieta, V.; Camacho-López, M.A.; Gómez-Espinosa, R.M.; Camacho-López, M.A.; Arenas-Alatorre, J.A. Solventless synthesis and optical properties of Au and Ag nanoparticles using Camellia sinensis extract. Mater. Lett. 2008, 62, 3103–3105. [Google Scholar] [CrossRef]
- Schneider, R.; Felix, J.F.; Moura, L.G.; Morais, P.C. One step fabrication of glass–silver@core–shell fibers: Silver-doped phosphate glasses as precursors of SERS substrates. J. Mater. Chem. C 2014, 2, 9021–9027. [Google Scholar] [CrossRef]
- Li, X.; Xu, H.; Chen, Z.S.; Chen, G. Biosynthesis of Nanoparticles by Microorganisms and Their Applications. J. Nanomater. 2011, 2011, 1–16. [Google Scholar] [CrossRef]
- Lu, X.; Rycenga, M.; Skrabalak, S.E.; Wiley, B.; Xia, Y. Chemical Synthesis of Novel Plasmonic Nanoparticles. Annu. Rev. Phys. Chem. 2009, 60, 167–192. [Google Scholar] [CrossRef]
- Dubey, S.P.; Lahtinen, M.; Sillanpää, M. Green synthesis and characterizations of silver and gold nanoparticles using leaf extract of Rosa rugosa. Colloids Surf. Physicochem. Eng. Asp. 2010, 364, 34–41. [Google Scholar] [CrossRef]
- Carmona, E.R.; Benito, N.; Plaza, T.; Recio-Sánchez, G. Green synthesis of silver nanoparticles by using leaf extracts from the endemic Buddleja globosa hope. Green Chem. Lett. Rev. 2017, 10, 250–256. [Google Scholar] [CrossRef]
- Gómez-Garzón, M. Nanomateriales, Nanopartículas y Síntesis verde. Rev. Repert. Med. Cir. 2018, 27. [Google Scholar] [CrossRef]
- Njagi, E.C.; Huang, H.; Stafford, L.; Genuino, H.; Galindo, H.M.; Collins, J.B.; Hoag, G.E.; Suib, S.L. Biosynthesis of Iron and Silver Nanoparticles at Room Temperature Using Aqueous Sorghum Bran Extracts. Langmuir 2010, 27, 264–271. [Google Scholar] [CrossRef] [PubMed]
- Bhattacharya, D.; Gupta, R.K. Nanotechnology and Potential of Microorganisms. Crit. Rev. Biotechnol. 2005, 25, 199–204. [Google Scholar] [CrossRef] [PubMed]
- Santos, A.; Troncoso, C.; Lamilla, C.; Llanquinao, V.; Pavez, M.; Barrientos, L. Nanopartículas Sintetizadas por Bacterias Antárticas y sus Posibles Mecanismos de Síntesis. Int. J. Morphol. 2017, 35, 26–33. [Google Scholar] [CrossRef]
- Kumar, B.; Smita, K.; Cumbal, L.; Debut, A. Green synthesis of silver nanoparticles using Andean blackberry fruit extract. Saudi J. Biol. Sci. 2017, 24, 45–50. [Google Scholar] [CrossRef] [PubMed]
- Makarov, V.; Love, A.; Sinitsyna, O.; Makarova, S.; Yaminsky, I.; Taliansky, M.; Kalinina, N. “Green” nanotechnologies: Synthesis of metal nanoparticles using plants. Acta Naturae 2014, 6, 35–44. [Google Scholar] [CrossRef]
- Mukherjee, P.; Ahmad, A.; Mandal, D.; Senapati, S.; Sainkar, S.R.; Khan, M.I.; Parishcha, R.; Ajaykumar, P.V.; Alam, M.; Kumar, R.; et al. Fungus-Mediated Synthesis of Silver Nanoparticles and Their Immobilization in the Mycelial Matrix: A Novel Biological Approach to Nanoparticle Synthesis. Nano Lett. 2001, 1, 515–519. [Google Scholar] [CrossRef]
- Balasooriya, E.R.; Jayasinghe, C.D.; Jayawardena, U.A.; Ruwanthika, R.W.D.; de Silva, R.M.; Udagama, P.V. Honey Mediated Green Synthesis of Nanoparticles: New Era of Safe Nanotechnology. J. Nanomater. 2017, 2017, 5919836. [Google Scholar] [CrossRef]
- Love, A.J.; Makarov, V.; Yaminsky, I.; Kalinina, N.O.; Taliansky, M.E. The use of tobacco mosaic virus and cowpea mosaic virus for the production of novel metal nanomaterials. Virology 2014, 449, 133–139. [Google Scholar] [CrossRef]
- Benakashani, F.; Allafchian, A.; Jalali, S.A.H. Green synthesis, characterization and antibacterial activity of silver nanoparticles from root extract of weed. Green Chem. Lett. Rev. 2017, 10, 324–330. [Google Scholar] [CrossRef]
- Avoseh, O.N.; Oyedeji, O.O.; Aremu, O.; Nkeh-Chungag, B.N.; Songca, S.P.; Oyedeji, A.O.; Mohan, S.; Oluwafemi, O.S. Biosynthesis of silver nanoparticles from Acacia mearnsii De Wild stem bark and its antinociceptive properties. Green Chem. Lett. Rev. 2017, 10, 59–68. [Google Scholar] [CrossRef]
- Azarbani, F.; Shiravand, S. Green synthesis of silver nanoparticles by Ferulago macrocarpa flowers extract and their antibacterial, antifungal and toxic effects. Green Chem. Lett. Rev. 2020, 13, 41–49. [Google Scholar] [CrossRef]
- Dubey, S.P.; Lahtinen, M.; Sillanpää, M. Tansy fruit mediated greener synthesis of silver and gold nanoparticles. Process Biochem. 2010, 45, 1065–1071. [Google Scholar] [CrossRef]
- Nadagouda, M.N.; Iyanna, N.; Lalley, J.; Han, C.; Dionysiou, D.D.; Varma, R.S. Synthesis of Silver and Gold Nanoparticles Using Antioxidants from Blackberry, Blueberry, Pomegranate, and Turmeric Extracts. ACS Sustain. Chem. Eng. 2014, 2, 1717–1723. [Google Scholar] [CrossRef]
- Soshnikova, V.; Kim, Y.J.; Singh, P.; Huo, Y.; Markus, J.; Ahn, S.; Castro-Aceituno, V.; Kang, J.; Chokkalingam, M.; Mathiyalagan, R.; et al. Cardamom fruits as a green resource for facile synthesis of gold and silver nanoparticles and their biological applications. Artif. Cells Nanomed. Biotechnol. 2017, 46, 108–117. [Google Scholar] [CrossRef] [PubMed]
- Chokkalingam, M.; Singh, P.; Huo, Y.; Soshnikova, V.; Ahn, S.; Kang, J.; Mathiyalagan, R.; Kim, Y.J.; Yang, D.C. Facile synthesis of Au and Ag nanoparticles using fruit extract of Lycium chinense and their anticancer activity. J. Drug Deliv. Sci. Technol. 2019, 49, 308–315. [Google Scholar] [CrossRef]
- Huong, V.T.L.; Nguyen, N.T. Green synthesis, characterization and antibacterial activity of silver nanoparticles using Sapindus mukorossi fruit pericarp extract. Mater. Today Proc. 2021, 42, 88–93. [Google Scholar] [CrossRef]
- Niluxsshun, M.C.D.; Masilamani, K.; Mathiventhan, U. Green Synthesis of Silver Nanoparticles from the Extracts of Fruit Peel of Citrus tangerina, Citrus sinensis, and Citrus limon for Antibacterial Activities. Bioinorg. Chem. Appl. 2021, 2021, 6695734. [Google Scholar] [CrossRef]
- Shankar, S.; Ahmad, A.; Sastry, M. Geranium Leaf Assisted Biosynthesis of Silver Nanoparticles. Biotechnol. Prog. 2003, 19, 1627–1631. [Google Scholar] [CrossRef]
- Jha, A.K.; Prasad, K.; Kumar, V.; Prasad, K. Biosynthesis of silver nanoparticles using Eclipta leaf. Biotechnol. Prog. 2009, 25, 1476–1479. [Google Scholar] [CrossRef]
- Song, J.Y.; Kim, B.S. Rapid biological synthesis of silver nanoparticles using plant leaf extracts. Bioprocess Biosyst. Eng. 2008, 32, 79–84. [Google Scholar] [CrossRef]
- Begum, N.A.; Mondal, S.; Basu, S.; Laskar, R.A.; Mandal, D. Biogenic synthesis of Au and Ag nanoparticles using aqueous solutions of Black Tea leaf extracts. Colloids Surf. B Biointerfaces 2009, 71, 113–118. [Google Scholar] [CrossRef] [PubMed]
- Dwivedi, A.D.; Gopal, K. Biosynthesis of silver and gold nanoparticles using Chenopodium album leaf extract. Colloids Surf. A Physicochem. Eng. Asp. 2010, 369, 27–33. [Google Scholar] [CrossRef]
- Schmidt-Lebuhn, A. Ethnobotany, biochemistry and pharmacology of Minthostachys (Lamiaceae). J. Ethnopharmacol. 2008, 118, 343–353. [Google Scholar] [CrossRef] [PubMed]
- Svendsen, A.B.; Scheffer, J.J.C.; Looman, A. Composition of the volatile oil of Minthostachys glabrescens epl. Flavour Fragr. J. 1987, 2, 45–46. [Google Scholar] [CrossRef]
- Pino, J.A.; Dueñas-Mendoza, M.M.; Solís-Quispe, L. Chemical Composition of the Essential Oil from Minthostachys acris Schmidt-Leb. Grown in the Peruvian Andes. Nat. Prod. Commun. 2019, 14, 1934578X1985749. [Google Scholar] [CrossRef]
- Yapuchura Mamani, R. Estudio de los Componentes Antioxidantes de las Hojas de Muña (Minthostachys mollis (Kunth) Griseb.) E inca muña (Clinopodium bolivianum (benth.) Kuntze). Master’s Thesis, Universidad Nacional Agraria La Molina, Lima, Peru, 2010. [Google Scholar]
- Serrano, C.A.; Villena, G.K.; Rodríguez, E.F. Phytochemical profile and rosmarinic acid purification from two Peruvian Lepechinia Willd. species (Salviinae, Mentheae, Lamiaceae). Sci. Rep. 2021, 11, 7260. [Google Scholar] [CrossRef]
- Serrano, C.A.; Villena, G.K.; Rodríguez, E.F.; Calsino, B.; Ludeña, M.A.; Ccana-Ccapatinta, G.V. Phytochemical analysis for ten Peruvian Mentheae (Lamiaceae) by liquid chromatography associated with high resolution mass spectrometry. Sci. Rep. 2023, 13, 10714. [Google Scholar] [CrossRef]
- Althubiti, A.A.; Alsudir, S.A.; Alfahad, A.J.; Alshehri, A.A.; Bakr, A.A.; Alamer, A.A.; Alrasheed, R.H.; Tawfik, E.A. Green Synthesis of Silver Nanoparticles Using Jacobaea maritima and the Evaluation of Their Antibacterial and Anticancer Activities. Int. J. Mol. Sci. 2023, 24, 16512. [Google Scholar] [CrossRef]
- Venkataesan Kumari, B.; Mani, R.; Asokan, B.R.; Balakrishnan, K.; Ramasamy, A.; Parthasarathi, R.; Kandasamy, C.; Govindaraj, R.; Vijayakumar, N.; Vijayakumar, S. Green Synthesised Silver Nanoparticles Using Anoectochilus elatus Leaf Extract: Characterisation and Evaluation of Antioxidant, Anti-Inflammatory, Antidiabetic, and Antimicrobial Activities. J. Compos. Sci. 2023, 7, 453. [Google Scholar] [CrossRef]
- Hasim, H.; Rao, P.V.; Sekhar, A.C.; Muthuraju, S.; Asari, M.A.; Sirajudeen, K.N.S. Green synthesis and characterization of silver nanoparticles using Tualang honey and evaluation of their antioxidant activities. Adv. Nat. Sci. Nanosci. Nanotechnol. 2020, 11, 025010. [Google Scholar] [CrossRef]
- Cavassin, E.D.; de Figueiredo, L.F.P.; Otoch, J.P.; Seckler, M.M.; de Oliveira, R.A.; Franco, F.F.; Marangoni, V.S.; Zucolotto, V.; Levin, A.S.S.; Costa, S.F. Comparison of methods to detect the in vitro activity of silver nanoparticles (AgNP) against multidrug resistant bacteria. J. Nanobiotechnol. 2015, 13, 64. [Google Scholar] [CrossRef] [PubMed]
- Sharifi-Rad, M.; Pohl, P.; Epifano, F. Phytofabrication of Silver Nanoparticles (AgNPs) with Pharmaceutical Capabilities Using Otostegia persica (Burm.) Boiss. Leaf Extract. Nanomaterials 2021, 11, 1045. [Google Scholar] [CrossRef] [PubMed]
- Chouhan, S.; Guleria, S. Green synthesis of AgNPs using Cannabis sativa leaf extract: Characterization, antibacterial, anti-yeast and α-amylase inhibitory activity. Mater. Sci. Energy Technol. 2020, 3, 536–544. [Google Scholar] [CrossRef]
- Bauer, A.W.; Kirby, W.M.M.; Sherris, J.C.; Turck, M. Antibiotic Susceptibility Testing by a Standardized Single Disk Method. Am. J. Clin. Pathol. 1966, 45, 493–496. [Google Scholar] [CrossRef] [PubMed]
- Fernando, I.; Zhou, Y. Impact of pH on the stability, dissolution and aggregation kinetics of silver nanoparticles. Chemosphere 2019, 216, 297–305. [Google Scholar] [CrossRef]
- Pham, X.N.; Nguyen, H.T.; Pham, N.T. Green Synthesis and Antibacterial Activity of HAp@Ag Nanocomposite Using Centella asiatica (L.) Urban Extract and Eggshell. Int. J. Biomater. 2020, 2020, 8841221. [Google Scholar] [CrossRef]
- Aryan; Ruby; Mehata, M.S. Green synthesis of silver nanoparticles using Kalanchoe pinnata leaves (life plant) and their antibacterial and photocatalytic activities. Chem. Phys. Lett. 2021, 778, 138760. [Google Scholar] [CrossRef]
- Keat, C.L.; Aziz, A.; Eid, A.M.; Elmarzugi, N.A. Biosynthesis of nanoparticles and silver nanoparticles. Bioresour. Bioprocess. 2015, 2, 47. [Google Scholar] [CrossRef]
- Habeeb Rahuman, H.B.; Dhandapani, R.; Narayanan, S.; Palanivel, V.; Paramasivam, R.; Subbarayalu, R.; Thangavelu, S.; Muthupandian, S. Medicinal plants mediated the green synthesis of silver nanoparticles and their biomedical applications. IET Nanobiotechnology 2022, 16, 115–144. [Google Scholar] [CrossRef]
- Shankar, S.; Rai, A.; Ahmad, A.; Sastry, M. Rapid synthesis of Au, Ag, and bimetallic Au core–Ag shell nanoparticles using Neem (Azadirachta indica) leaf broth. J. Colloid Interface Sci. 2004, 275, 496–502. [Google Scholar] [CrossRef]
- Kelly, K.L.; Coronado, E.; Zhao, L.L.; Schatz, G.C. The Optical Properties of Metal Nanoparticles:The Influence of Size, Shape, and Dielectric Environment. J. Phys. Chem. B 2002, 107, 668–677. [Google Scholar] [CrossRef]
- Kramida, A.; Ralchenko, Y. NIST, Atomic Spectra Database, NIST Standard Reference Database. Available online: https://physics.nist.gov/asd (accessed on 10 November 2024).
- Sangameshwaran, V.; Ragu Prasath, A.; Selvam, K.; Obaidullah, A.J.; Kumar Yadav, K.; Sudhakar, C. Green synthesis of silver nanoparticles using Senna alexandrina leaf extracts and their antibacterial, larvicidal, nanotoxicity and photocatalytic activity. Inorg. Chim. Acta 2024, 571, 122220. [Google Scholar] [CrossRef]
- Revathi, S.; Sutikno, S.; Hasan, A.F.; Altemimi, A.B.; ALKaisy, Q.H.; Phillips, A.J.; Hesarinejad, M.A.; Abedelmaksoud, T.G. Green synthesis and characterization of silver nanoparticles (AgNP) using Acacia nilotica plant extract and their anti-bacterial activity. Food Chem. Adv. 2024, 4, 100680. [Google Scholar] [CrossRef]
- George, N.; Joy, J.; Mathew, B.; Koshy, E.P. Green mediated synthesis of silver nanoparticle using Euphorbia mculate leaf extract and their catalytic reduction and antibacterial properties. Mater. Today Proc. 2024. [Google Scholar] [CrossRef]
- Singh, R.; Singh, R.; Parihar, P.; Mani, J.V. Green synthesis of silver nanoparticles using Solanum sisymbriifolium leaf extract: Characterization and evaluation of antioxidant, antibacterial and photocatalytic degradation activities. Process Biochem. 2024, 143, 337–352. [Google Scholar] [CrossRef]
- Alotaibi, N.F.; ALqarni, L.S.; Alghamdi, S.Q.; Al-Ghamdi, S.N.; Amna, T.; Alzahrani, S.S.; Moustafa, S.M.; Hasanin, T.H.; Nassar, A.M. Green Synthesis of Uncoated and Olive Leaf Extract-Coated Silver Nanoparticles: Sunlight Photocatalytic, Antiparasitic, and Antifungal Activities. Int. J. Mol. Sci. 2024, 25, 3082. [Google Scholar] [CrossRef]
- Sultan, M.; Siddique, M.; Khan, R.; Fallatah, A.M.; Fatima, N.; Shahzadi, I.; Waheed, U.; Bilal, M.; Ali, A.; Abbasi, A.M. Ligustrum lucidum Leaf Extract-Assisted Green Synthesis of Silver Nanoparticles and Nano-Adsorbents Having Potential in Ultrasound-Assisted Adsorptive Removal of Methylene Blue Dye from Wastewater and Antimicrobial Activity. Materials 2022, 15, 1637. [Google Scholar] [CrossRef]
- Sahu, K.; Kurrey, R.; Pillai, A.K. Green synthesis of silver nanoparticles from Manilkara zapota leaf extract for the detection of aminoglycoside antibiotics and other applications. RSC Adv. 2024, 14, 23240–23256. [Google Scholar] [CrossRef]
- Chinnathambi, A.; Alharbi, S.A.; Joshi, D.; V, S.; Jhanani, G.; On-uma, R.; Jutamas, K.; Anupong, W. Synthesis of AgNPs from leaf extract of Naringi crenulata and evaluation of its antibacterial activity against multidrug resistant bacteria. Environ. Res. 2023, 216, 114455. [Google Scholar] [CrossRef]
- Bhusal, M.; Pathak, I.; Bhadel, A.; Shrestha, D.K.; Sharma, K.R. Synthesis of silver nanoparticles assisted by aqueous root and leaf extracts of Rhus chinensis Mill and its antibacterial activity. Heliyon 2024, 10, e33603. [Google Scholar] [CrossRef]
- Islam, M.J.; Khatun, N.; Bhuiyan, R.H.; Sultana, S.; Ali Shaikh, M.A.; Amin Bitu, M.N.; Chowdhury, F.; Islam, S. Psidium guajava leaf extract mediated green synthesis of silver nanoparticles and its application in antibacterial coatings. RSC Adv. 2023, 13, 19164–19172. [Google Scholar] [CrossRef] [PubMed]
- Zargar, M.; Hamid, A.A.; Bakar, F.A.; Shamsudin, M.N.; Shameli, K.; Jahanshiri, F.; Farahani, F. Green Synthesis and Antibacterial Effect of Silver Nanoparticles Using Vitex negundo L. Molecules 2011, 16, 6667–6676. [Google Scholar] [CrossRef] [PubMed]
- Jayaprakash, N.; Vijaya, J.J.; Kaviyarasu, K.; Kombaiah, K.; Kennedy, L.J.; Ramalingam, R.J.; Munusamy, M.A.; Al-Lohedan, H.A. Green synthesis of Ag nanoparticles using Tamarind fruit extract for the antibacterial studies. J. Photochem. Photobiol. B Biol. 2017, 169, 178–185. [Google Scholar] [CrossRef] [PubMed]











| Leaf Extract | Extract | AgNPs | Ref. | |
|---|---|---|---|---|
| Solvent | Temperature (°C) | |||
| Minthostcahys acris | distilled water | room | like-spherical | This work |
| Cannabis sativa | distilled water | 60 °C | spherical | [44] |
| Senna alexandrina | distilled water | 90 °C | spherical | [54] |
| Acacia nilotica | distilled water | 60 °C | spherical | [55] |
| Euphorbia Maculate | deionized water | 100 °C | spherical | [56] |
| Solanum sisymbriifolium | distilled water | 50–60 °C | spherical | [57] |
| Olea europaea L. | distilled water | 100 °C | asymmetrical | [58] |
| Jacobaea maritima | distilled water | 100 °C | spherical | [39] |
| Anoectochilus elatus | distilled water | 100 °C | spherical | [40] |
| Ligustrum lucidum | methanol | 25 ± 5 °C | spherical | [59] |
| Manilkara zapota | Milli-Q water | 80 °C | spherical | [60] |
| Naringi crenulata | methanol | 64 °C | spherical | [61] |
| Rhus chinensis | deionized water | 60 °C | spherical | [62] |
| Psidium guajava | deionized water | 90 °C | spherical | [63] |
| Time (min) | Agitation | Halo (mm) | Immersion | Halo (mm) |
|---|---|---|---|---|
| 0 |  | - |  | - |
| 0.5 | | 18.705 ± 0.72 CV = 3.850 a c |  | 17.753 ± 0.73 CV = 4.120 a e |
| 1 | | 17.313 ± 0.56 CV = 3.251 a |  | 19.472 ± 0.46 CV = 2.374 b c d e |
| 3 |  | 17.878 ± 0.56 CV = 3.145 a | | 20.107 ± 0.16 CV = 0.814 c b d e |
| 6 | | 21.33 ± 0.48 CV = 2.250 b c |  | 20.587 ± 0.12 CV = 0.606 d c e |
| 10 | | 20.432 ± 0.84 CV = 4.147 a b c | | 18.317 ± 0.15 CV = 0.833 e a |
| Time (min) | Agitation | Halo (mm) | Immersion | Halo (mm) |
|---|---|---|---|---|
| 0 |  | - |  | - |
| 0.5 |  | 18.683 ± 0.48 CV = 2.584 a |  | 20.375 ± 0.37 CV = 3.251 a e |
| 1 |  | 22.753 ± 0.58 CV = 2.5582 a |  | 21.011 ± 0.89 CV = 3.374 b c d e |
| 3 |  | 20.866 ± 0.37 CV = 13.507 a |  | 22.826 ± 0.54 CV = 2.250 c d e |
| 6 |  | 21.586 ± 0.80 CV = 11.585 a |  | 23.85 ± 0.87 CV = 0.606 d b c e |
| 10 |  | 22.57 ± 1.20 CV = 18.310 a |  | 22.14 ± 0.90 CV = 3.145 e a |
| Leaf Extract | AgNPs | E. coli | S. aureus | Reference |
|---|---|---|---|---|
| (L) | Halo (mm) | |||
| Minthostachys acris | spherical-like (20) | 21.33 ± 0.48 | 21.58 ± 0.80 | This work |
| Minthostachys acris | spherical-like (20) | 20.58 ± 0.12 | 23.85 ± 0.87 | This work |
| Cannabis sativa | spherical (20) | 28 | 12 | [44] |
| Acacia nilotica | spherical (100) | 25 | 20 | [55] |
| Anoectochilus elatus | spherical (25) | 15 ± 1.20 | 13 ± 1.04 | [40] |
| Otostegia persica | spherical (50) | 16 ± 0.2 | 15 ± 0.3 | [43] |
| Otostegia persica | spherical (100) | 17 ± 0.1 | 16 ± 0.1 | [43] |
| Vitex negundo L. | spherical (20) | 12.0 ± 0.7 | 11.0 ± 0.3 | [64] |
Disclaimer/Publisher’s Note: The statements, opinions and data contained in all publications are solely those of the individual author(s) and contributor(s) and not of MDPI and/or the editor(s). MDPI and/or the editor(s) disclaim responsibility for any injury to people or property resulting from any ideas, methods, instructions or products referred to in the content. |
© 2024 by the authors. Licensee MDPI, Basel, Switzerland. This article is an open access article distributed under the terms and conditions of the Creative Commons Attribution (CC BY) license (https://creativecommons.org/licenses/by/4.0/).
Share and Cite
Ayma, F.C.; Osorio Anaya, A.M.; Peiter, G.C.; Jaerger, S.; Schneider, R. Green Synthesis and Characterization of Silver Nanoparticles from Minthostachys acris Schmidt Lebuhn (Muña) and Its Evaluation as a Bactericidal Agent Against Escherichia coli and Staphylococus aureus. Micro 2024, 4, 706-720. https://doi.org/10.3390/micro4040043
Ayma FC, Osorio Anaya AM, Peiter GC, Jaerger S, Schneider R. Green Synthesis and Characterization of Silver Nanoparticles from Minthostachys acris Schmidt Lebuhn (Muña) and Its Evaluation as a Bactericidal Agent Against Escherichia coli and Staphylococus aureus. Micro. 2024; 4(4):706-720. https://doi.org/10.3390/micro4040043
Chicago/Turabian StyleAyma, Fabián Ccahuana, Ana María Osorio Anaya, Gabrielle Caroline Peiter, Silvia Jaerger, and Ricardo Schneider. 2024. "Green Synthesis and Characterization of Silver Nanoparticles from Minthostachys acris Schmidt Lebuhn (Muña) and Its Evaluation as a Bactericidal Agent Against Escherichia coli and Staphylococus aureus" Micro 4, no. 4: 706-720. https://doi.org/10.3390/micro4040043
APA StyleAyma, F. C., Osorio Anaya, A. M., Peiter, G. C., Jaerger, S., & Schneider, R. (2024). Green Synthesis and Characterization of Silver Nanoparticles from Minthostachys acris Schmidt Lebuhn (Muña) and Its Evaluation as a Bactericidal Agent Against Escherichia coli and Staphylococus aureus. Micro, 4(4), 706-720. https://doi.org/10.3390/micro4040043






